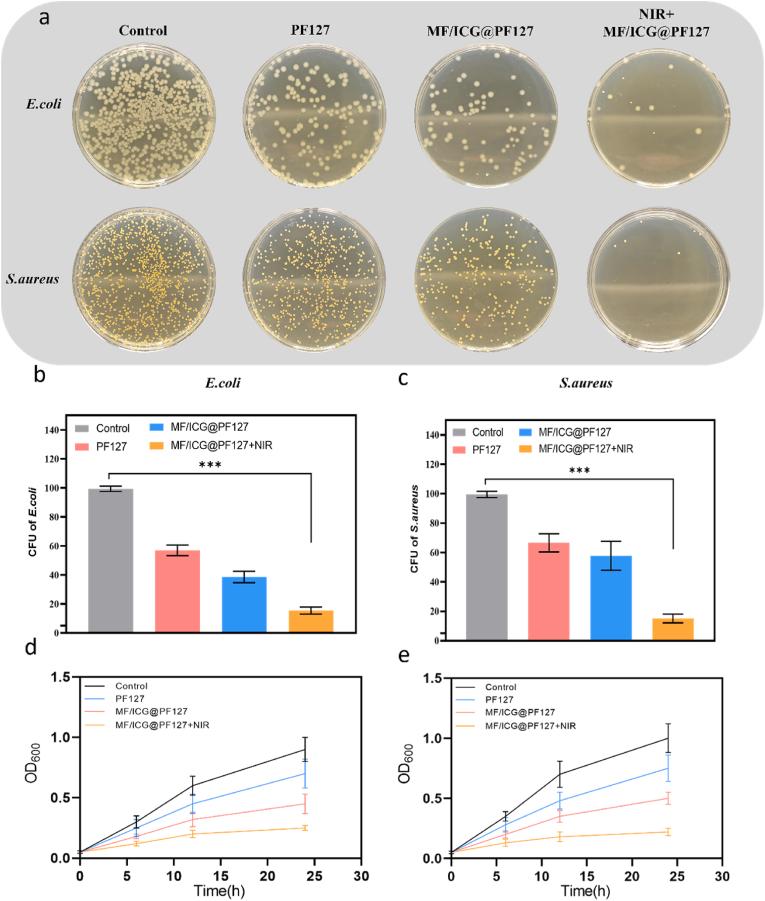
https://cdn.ncbi.nlm.nih.gov/pmc/blobs/833f/12318298/d5639d2a0b1a/gr4.jpg

一种智能的基于锰硅酸盐的一氧化碳释放水凝胶通过近红外触发的抗菌、抗炎和促再生机制促进糖尿病伤口愈合。
A smart CO-releasing MnSiO-based hydrogel enhances diabetic wound healing through NIR-triggered antibacterial, anti-inflammatory, and pro-regenerative mechanisms.
作者信息
Liu Yukun, Gao Fangli, Liu Shuai, Xu Zhikai, Zhao Xuan, Yang Fan, Li Zhanfei, Bai Xiangjun, Zhu Liang, Mi Bobin, Wang Yuchang
机构信息
Department of Plastic and Aesthetic Surgery, Tongji Hospital, Tongji Medical College, Huazhong University of Science and Technology, Wuhan, 430030, China.
College of Chemistry and Chemical Engineering, Henan Normal University, Xinxiang, 4453007, China.
出版信息
Mater Today Bio. 2025 Jul 22;34:102084. doi: 10.1016/j.mtbio.2025.102084. eCollection 2025 Oct.
Diabetes is a growing global health concern often associated with chronic wounds characterized by persistent infection, excessive inflammation, and impaired angiogenesis. To address these challenges, we developed a multifunctional hydrogel MnSiO-Fe(CO)/ICG@PF127 (MF/ICG@PF127) that combines photothermal and photodynamic antibacterial effects, controlled carbon monoxide (CO) release, and immunomodulatory activity to promote diabetic wound healing. This hydrogel was constructed by encapsulating Fe(CO) within MnSiO nanoparticles (MF) and co-assembling with indocyanine green (ICG) into a thermosensitive Pluronic F127 matrix ), forming a near-infrared (NIR)-responsive platform. In vitro, MF/ICG@PF127 exhibited excellent biocompatibility, potent antibacterial activity under NIR irradiation, and effective suppression of inflammatory cytokines (IL-6, iNOS, IL-1β). It also enhanced fibroblast and endothelial cell migration and tube formation. In vivo, NIR-activated MF/ICG@PF127 significantly accelerated wound closure and tissue regeneration in diabetic mice. Immunofluorescence showed enhanced M2 macrophage polarization and reduced inflammation. Transcriptomic analysis revealed activation of the Wnt/β-catenin signaling pathway and upregulation of angiogenic (VEGFR2) and proliferative markers (Cyclin D1, c-Myc). These synergistic effects highlight MF/ICG@PF127 hydrogel as a promising strategy for remodeling the diabetic wound microenvironment and facilitating chronic wound repair.
糖尿病是一个日益严重的全球健康问题,常与慢性伤口相关,其特征为持续感染、过度炎症反应和血管生成受损。为应对这些挑战,我们开发了一种多功能水凝胶MnSiO-Fe(CO)/ICG@PF127(MF/ICG@PF127),它结合了光热和光动力抗菌作用、可控的一氧化碳(CO)释放以及免疫调节活性,以促进糖尿病伤口愈合。这种水凝胶是通过将Fe(CO)封装在MnSiO纳米颗粒(MF)中,并与吲哚菁绿(ICG)共同组装到热敏性泊洛沙姆F127基质中构建而成,形成了一个近红外(NIR)响应平台。在体外,MF/ICG@PF127表现出优异的生物相容性,在近红外照射下具有强大的抗菌活性,并能有效抑制炎症细胞因子(IL-6、诱导型一氧化氮合酶、IL-1β)。它还增强了成纤维细胞和内皮细胞的迁移以及血管生成。在体内,近红外激活的MF/ICG@PF127显著加速了糖尿病小鼠伤口的闭合和组织再生。免疫荧光显示M2巨噬细胞极化增强且炎症减轻。转录组分析揭示了Wnt/β-连环蛋白信号通路的激活以及血管生成(血管内皮生长因子受体2)和增殖标志物(细胞周期蛋白D1、c-Myc)的上调。这些协同效应突出了MF/ICG@PF127水凝胶作为重塑糖尿病伤口微环境和促进慢性伤口修复的一种有前景策略的作用。